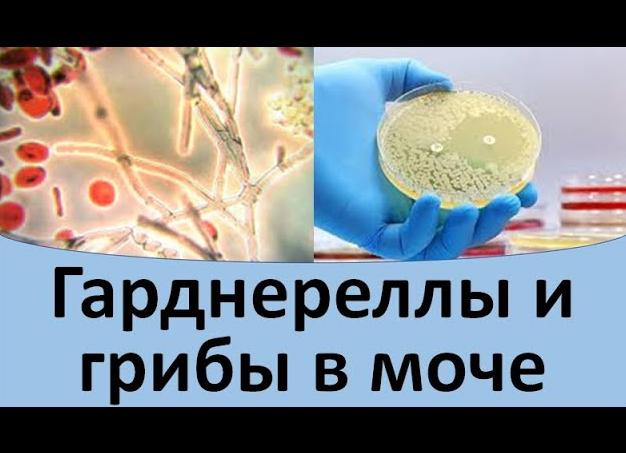
Гарднерелла в моче

[Гарднерелла в моче]
[Гарднерелла в моче]
Симптомы и лечение гарднереллеза у женщин, влияние заболевания на беременность
Во влагалище в норме существуют разнообразные микроорганизмы: лакто и бифидобактерии, которые составляют до 95% всей микрофлоры половых путей, а также кокки, энтеробактерии, кишечная палочка, грибки рода Candida, клебсиелла, микоплазма и другие, в том числе и гарднерелла.
Что такое гарднерелла?
Это бактерии рода Gardnerella, включающего только один вид – Gardnerella vaginalis. В небольшом количестве эти микроорганизмы присутствуют в составе обычной микробной ассоциации, живущей во влагалище здоровой женщины. Они представляют собой факультативные анаэробы, то есть могут существовать в среде без доступа кислорода.
В благоприятных для себя условиях микробы быстро размножаются в уретре и влагалище, подавляя и уничтожая молочнокислые бактерии. Развивается заболевание, которое раньше называли гарднереллез. Сейчас ученые выяснили, что в этом процессе активно участвуют и другие условно-патогенные микробы – микоплазма и облигатные анаэробы, способные существовать только в бескислородной среде (фузобактерии, бактероиды, пептострептококки и другие). Таким образом, гарднереллез у женщин по современным понятиям — смешанная инфекция. В настоящее время это заболевание предпочитают называть «бактериальный вагиноз».
Этот диагноз отсутствует в Международной классификации болезней 10 пересмотра, поскольку сам термин «бактериальный вагиноз» вошел в практику позже создания этой классификации.
Причины и механизм развития заболевания
Гарднереллез – это не воспалительное заболевание, а нарушение баланса микрофлоры влагалища, то есть влагалищный дисбиоз. Это состояние хотя бы один раз в жизни развивается у трети женщин. Опасен ли он? Бактериальный вагиноз создает благоприятные условия для формирования инфекций половых путей – хламидиоза, неспецифического вагинита, кольпита и других. Он способствует формированию предракового состояния шейки матки – дисплазии. Гарднереллез повышает риск неблагоприятного исхода гинекологических вмешательств, абортов и родов. Он увеличивает вероятность заражения ВИЧ-инфекцией.
Причины возникновения гарднереллеза у женщин:
- использование антибактериальных препаратов, прежде всего антибиотиков, а также местных антисептиков, например, во время спринцевания;
- бесконтрольный прием оральных противозачаточных средств и спермицидов;
- внутриматочная контрацепция без должного врачебного наблюдения;
- гормональные расстройства, сопровождающиеся уменьшением объема крови, выделяемой при менструации, а также удлинением менструального цикла, при половом созревании или менопаузе;
- воспалительные заболевания нижних половых органов, матки, придатков;
- беспорядочные половые связи;
- иммунодефицитные состояния при сахарном диабете, приеме иммунодепрессантов и цитостатиков, ВИЧ-инфекции;
- пороки развития, полипы, кисты, инородные тела влагалища и матки.
При избыточном росте условно-патогенных микробов во влагалище меняется кислотность его внутренней среды, рН повышается до 7 и более. В этих условиях ослабевает естественная защита половых органов, присоединяются инфекционные осложнения. Таким образом, причины гарднереллеза приводят не только к развитию бактериального вагиноза, но и способствуют заселению влагалища болезнетворными микроорганизмами.
Гарднереллез у мужчин встречается значительно реже. Обычно эти микробы удаляются из уретры с потоком мочи. Описаны единичные случаи воспалительного поражения половых органов мужчины гарднереллами. Однако каждый десятый зараженный мужчина становится носителем инфекции, распространяя ее при незащищенных половых контактах. При этом внешние проявления болезни у него отсутствуют.
Клиническая картина и диагностика
Время от начала заболевания до формирования первых признаков в большинстве случаев равно 10 дням.
Симптомы гарднереллеза
Появляются довольно обильные выделения из влагалища, зуд, жжение. Выделения обычно имеют белый или серый цвет, они липкие, однородные, пенистые, с характерным неприятным рыбным запахом. Они наблюдаются у половины больных, раздражают стенки половых органов, иногда вызывая жжение и зуд. Возможно усиление неприятных ощущений во время полового контакта или менструального кровотечения.
Такие симптомы могут сохраняться очень долго, даже на протяжении многих лет. При таком длительном процессе выделения приобретают творожистый характер и желто-зеленый цвет.
У каждой пятой пациентки появляются нарушения мочеиспускания: оно может быть частым, болезненным, малыми порциями, сопровождаться зудом. При этом гарднереллы из мочи выделяются практически у всех женщин с бактериальным вагинозом.
Особенностью вагиноза является отсутствие отека и покраснения стенок влагалища, то есть воспаления. Однако почти у половины пациенток есть сопутствующие заболевания шейки: воспаление, рубцовая деформация, эктропион, псевдоэрозия.
Постановка диагноза
При подобных признаках врач может поставить предварительный диагноз с помощью следующих методов:
- определение реакции влагалищного содержимого (рН-метрия), при которой определяется щелочная реакция, в отличие от нормальной – кислой, создающейся молочнокислыми бактериями;
- положительная аминная реакция: при смешивании выделений с раствором гидроксида калия возникает сильный неприятный рыбный запах.
Диагноз подтверждается при исследовании окрашенных мазков под микроскопом. Определяются следующие специфичные признаки гарднереллеза:
- большое число слущенных клеток, выстилающих слизистую;
- «ключевые клетки» — эпителиоциты с фиксированными на них гарднереллами и другими микробами;
- отсутствие молочнокислых палочек;
- наличие гарднерелл, бактероида, фузобактерий и других возбудителей вагиноза;
- небольшое число лейкоцитов, свидетельствующее о слабо выраженном воспалении.
Существуют и другие методы диагностики: реакция иммунофлюоресценции, полимеразная цепная реакция, ДНК-гибридизация, а также культивирование микроорганизмов. Они направлены на выявление гарднерелл во влагалищном содержимом. Эти методы дороги, часто трудоемки и экономически неэффективны, поэтому они применяются редко.
Особенности течения болезни у беременных
Гарднерелла при беременности встречается реже, чем вне этого состояния, что обусловлено физиологическим увеличением количества лактобацилл у будущей мамы. Они призваны создавать кислую среду во влагалище. Тем самым лактобактерии защищают плод от проникновения через шейку матки инфекционных агентов.
Диагностике и лечению гарднереллеза у беременных нужно уделять особое внимание, так как он может вызывать осложнения беременности (хориоамнионит, прерывание на ранних сроках, учащение в два раза вероятности преждевременных родов, послеродовый эндометрит и сепсис). Влияние на плод напрямую обычно отсутствует, однако повышенная частота преждевременных родов ведет к появлению на свет недоношенных детей.
Таким образом, нелеченый гарднереллез во время беременности не является безобидным состоянием, он опасен для женщины и ее будущего ребенка. Это состояние обязательно нужно лечить. Лечение затрудняется тем, что многие антибактериальные препараты во время беременности (особенно в течение первого триместра) противопоказаны.
Терапия
Во время курса терапии гарднереллеза женщине рекомендуется отказаться от жирной и сладкой пищи, принимать больше жидкости, кисломолочных продуктов, нормализовать стул при помощи растительной клетчатки (овощей). Пациентка может мыться под душем, посещать баню, но не париться. Следует отказаться от приема ванн.
Лечение полового партнера проводится лишь в том случае, если у него обнаружено воспаление мочеиспускательного канала – уретрит. В остальных ситуациях лекарства мужчине не назначаются. Желательно использование презервативов, чтобы снизить риск заражения другими инфекционными заболеваниями от партнера, хотя согласно некоторым рекомендациям оно необязательно. Бактериальный вагиноз не передается половым путем.
Лечить заболевание нужно во всех случаях, особенно перед проведением абортов.
Лечение гарднереллеза основано на следующих принципах:
- антибактериальная терапия;
- нормализация микробной флоры влагалища;
- укрепление иммунитета и профилактика рецидивов.
При гарднереллезе не применяются тетрациклины, цефалоспорины, аминогликозиды. Основа лечения – Метронидазол, реже применяются Ампициллин и Клиндамицин.
Эти препараты можно использовать как в виде таблеток, так и местно. Внутрь назначают Метронидазол или Клиндамицин в течение недели. В течение этого времени и последующих суток женщине запрещено употреблять спиртные напитки.
Хорошо себя зарекомендовали свечи Тержинан, их нужно использовать в течение десяти дней. Применяется Метронидазол-гель, вагинальный крем Клеоцин. Одновременно с этими лекарствами для профилактики кандидоза назначаются антигрибковые препараты, в частности, Флуконазол для приема внутрь или местного использования.
Лечение гарднереллеза при беременности проводится с использованием местных препаратов, поскольку системные средства могут навредить ребенку. Во 2 и 3 триместрах хорошо себя зарекомендовал вагинальный крем Далацин с содержанием клиндамицина. Дополнительно для профилактики кандидоза беременным назначают свечи Натальсид, Пимафуцин, Гино-певарил.
Параллельно с применением антибиотиков можно использовать и антисептические средства для местного применения, например, Бетадин (Повидон-йод), Хлоргексидин. Это ускорит выздоровление.
Через 3 дня после окончания курса противомикробной терапии назначают средства, восстанавливающие нормальную кисломолочную флору влагалища – Ацилакт (таблетки, свечи, порошок для приготовления суспензии), Лактобактерин. Для восстановления бифидобактерий применяют Бифидумбактерин. Можно назначать и комбинированные средства, например, Линекс, Бифилиз и другие. Их можно использовать и внутрь, и местно, учитывая тот факт, что бактериальный вагиноз очень часто сочетается с нарушением состава кишечной микрофлоры. Одновременно назначаются поливитаминные комплексы.
Для профилактики и лечения рецидивирующего гарднереллеза используется вакцина Солкотриховак. Она усиливает местные иммунные реакции, способствует развитию лактобацилл, подавляет размножение условно-патогенной флоры. Существуют особенности введения вакцины, поэтому назначать и контролировать лечение ей должен только врач.
Лечение в домашних условиях должно осуществляться по назначению врача. Дополнительно после стихания обострения можно проводить спринцевания с ромашкой, корой дуба, соком алоэ, календулой и другими травами с противовоспалительными и антисептическими свойствами. Однако следует понимать: спринцевание вымывает полезные микроорганизмы, что может еще более затянуть выздоровление. Только народными средствами избавиться от гарднереллеза практически невозможно.
Обычно лечение занимает около 2 месяцев: 10 дней антибактериальной терапии с последующим восстановлением микрофлоры половых путей. Оценка эффективности терапии проводится после полного исчезновения симптомов.
Профилактика включает следующие направления:
- достижение нормального гормонального фона;
- лечение антибиотиками только по назначению врача;
- соблюдение обычных правил личной гигиены, без частых спринцеваний;
- отказ от половых контактов с разными партнерами;
- лечение дисбактериоза кишечника и инфекций мочеполовой системы.
При выполнении всех рекомендаций врача по образу жизни и лечению прогноз для жизни и здоровья женщины хороший, после окончания курса лечения она избавится от гарднереллеза.
Обнаружение Gardnerella vaginalis (в моче, ПЦР)
Гарднерелла (Gardnerella vaginalis) – бактерия, относящаяся к роду Gardnerella. Средой обитания является мочеполовой тракт человека.
Гарднереллез (бактериальный вагиноз), — это заболевание, при котором в организме человека увеличивается количество гарднерелл. Гарднереллезом болеют в основном женщины, в мужском организме гарднереллы, как правило, долго не существуют. Гарднерелла не относится к классическим венерическим болезням. В небольшом количестве гарднереллы присутствуют во влагалище многих здоровых женщин. Гарднереллез часто встречается у беременных женщин. В норме их количество незначительно. Поэтому применение метода ПЦР часто дает отрицательный результат.
Гарднереллы входят в биоценоз влагалища и являются частью его нормальной микрофлоры. Кроме гарднерелл во влагалище женщины находятся также и другие бактерии. Из них более 90% составляет палочка Дедерляйна (относится к роду Lactobacillus), другую большую часть занимают бифидобактерии. В небольших количествах во влагалище могут присутствувать и другие бактерии (мобилункус), а также грибы рода Кандида. В сумме они составляют нормальную микрофлору влагалища женщины.
Вместо устаревшего диагноза «гарднереллез», используют диагноз « бактериальный вагиноз», который подразумевает замещение нормальной флоры влагалища различными бактериями, включая и гарднереллу.
Основной путь передачи – половой. Возможен также вертикальный путь передачи при прохождении новорожденной девочки по половым путям матери. Нарушением нормальной микрофлоры влагалища может происходить по разным причинам. Наибольшее значение отводят снижению иммунитета, изменениям в гормональном фоне (беременность, роды, аборт, половое созревание), воспалительным процессам. Гарднереллёз может быть причиной осложнений при беременности, воспалительных заболеваний, послеродового эндометрита, маточных кровотечений.
Гарднереллёз, чаще выявляется у женщин детородного возраста. Заболевание возникает как следствие резкого нарушения баланса микрофлоры влагалища. Преобладающие в норме лактобактерии замещаются анаэробными микроорганизмами. Нужно учитывать, часть женщин, не страдающих бактериальным вагинозом имеют высокий уровень этих микробов во влагалищном секрете.
У мужчин гарднерелла попадает половым путем, но редко является причиной заболеваний урогенитального тракта и выводится в течении 2-3 дней. Реже возникает носительство, без симптомов заболевания, но с положительным результатом исследования на гарднереллу.
Диагностика гарднереллеза не заканчивается обнаружением гарднерелл. Необходим поиск сопутствующих возбудителей, которые в большинстве случаев приводят к воспалительному процессу.
Нормы анализов на гарднереллу у женщин
Гарднерелла в мазке обнаруживается при нарушении нормальной микрофлоры мочеполовых органов. Это условно-патогенная бактерия, которая в незначительном количестве присутствует во влагалище и не вызывает нарушение микрофлоры. При превышении установленных норм приводит к обильным выделениям с неприятным запахом, зуду и жжению в половых органах.
Для определения отклонений от нормы проводится лабораторное исследование биологического материала, взятого из половых органов пациента.
Показания к назначению анализа
Для выявления гарднереллы у мужчин можно использовать урогенитальный мазок или утреннюю урину, у женщин берется мазок из влагалища.
Гинекологи государственных и частных клиник (Инвитро и другие) рекомендуют сдать анализ на гарднереллу, если у женщины:
- нарушена микрофлора влагалища;
- имеются чрезмерно обильные выделения из влагалища, которые сопровождаются появлением неприятного запаха;
- в ходе планового осмотра в мазке из половых органов обнаружены патогенные микроорганизмы;
- в планах беременность, такой анализ позволит своевременно выявить инфекцию и предотвратить развитие осложнений, которые она провоцирует;
- в период вынашивания плода сопровождается осложнениями.
Мужчине анализ для проверки гарднереллы назначается крайне редко, так как после проникновения в организм, ее активность подавляется в течение 48-72 часов. Реже мужчина может быть носителем патогенной флоры.
Необходимость своевременной диагностики обусловлена бессимптомным течением патологии и возможными осложнениями. У женщин гарднерелла может стать причиной:
- Вагиноза – патологическое состояние, которое характеризуется нарушением микрофлоры влагалища.
- Воспалительных заболеваний органов малого таза (цервицит, эндометрит, бартолинит), которые сопровождаются болевыми ощущениями и дискомфортом внизу живота, обильными выделениями белого, серого, зеленоватого, желтого оттенка.
- Воспаления плодных оболочек или оболочек матки в период вынашивания ребенка.
- Выкидыша во втором триместре беременности.
- Преждевременного родоразрешения.
- Маловесных детей.
Подготовка
Вне зависимости от показаний, по которым женщина направлена на анализ на выявление gardnerella vaginalis, необходимо правильно подготовиться к его проведению, что позволит получить достоверные результаты и, при необходимости, назначить корректную терапию.
С этой целью Инвитро и другие клиники, специализирующиеся на проведении подобных исследований, рекомендуют:
- минимум за 24 часа до проведения анализа отказаться от половых контактов;
- за сутки исключить спринцевание, использование медикаментозных препаратов, в особенности с антибактериальным эффектом, которые вводятся вагинально;
- исключить мочеиспускание за 3 часа до анализа, особенно это касается мужчин, так как урина обладает антисептическими свойствами и может значительно повлиять на результаты исследования;
- запланировать исследование до наступления менструации или сразу после нее, оптимальным днем считается 7-10 дни цикла;
- в день исследования проводить подмывания без использования мыла.
Причины появления гарднереллы в анализе и ее симптоматика
Гарднерелла вагиналис диагностируется более у 20% женщин в детородном возрасте. Основная причина роста бактерии – нарушение микрофлоры влагалища, что часто связано с использованием противозачаточных таблеток, вагинальных свечей и таблеток, спринцеванием, а также половой жизнью с частой сменой партнера без использования барьерных средств контрацепции.
Способствующими факторами к размножению гарднереллы у женщин являются:
- снижение местного и общего иммунитета;
- эндокринные расстройства, гормональный дисбаланс;
- нарушение микрофлоры кишечника;
- продолжительный курс антибактериальной терапии общего и местного действия;
- воспалительные патологии органов малого таза;
- прием гормональных медикаментов и антидепрессантов;
- злоупотребление алкоголем, курение;
- частые стрессы.
Возможные симптомы
В большинстве случаев гарднереллез носит бессимптомный характер и протекает без выраженной клинической картины. Микроорганизмы обнаруживаются в ходе клинического исследования мазка в ходе профилактического осмотра.
Реже вагиноз может иметь выраженные признаки:
- патологически обильные вязкие выделения из половых путей белого, желтого или серого оттенка с неприятным ароматом (запах тухлой рыбы);
- отек и покраснение слизистых влагалища на фоне обильного выделения секрета и его скопления на стенках;
- дискомфорт, зуд, жжение в промежности;
- сбои менструального цикла;
- боли во время половых контактов и при мочеиспускании;
- ухудшение общего состояния;
- воспалительные заболевания нижних органов мочевыделительной системы (цистит, уретрит) из-за близкой локализации половых органов.
Виды анализов на гарднереллез
Для диагностики женщине необходимо обратиться к гинекологу, мужчине к урологу, дерматовенерологу в кожно-венерологической поликлинике или в любой частной клинике, например Инвитро.
Для диагностики gardnerella vaginalis берется соскоб со слизистых оболочек половых органов. После мазок направляется в лабораторию на исследование, которое проводится одним из следующих способов:
- Микроскопический анализ проводится после высушивания и окрашивания биологического материала специальным методом, что позволяет обнаружить в мазке гарднереллы и другие патогенные микроорганизмы. В ходе исследования во внимание берутся клетки, находящиеся в поле зрения. Срок проведения колеблется от 1 до 3 дней.
- Бактериологический посев отличается высокой точностью и проводится в отношении конкретного микроорганизма. Для получения результатов биологический материал помещается в особую специально созданную среду, в которой гарднерелла вагиналис будет расти и размножаться. Емкость с исследуемым материалом помещается в термостат, который позволяет поддерживать необходимую температуру и влажность для выращивания флоры. Для определения устойчивости бактерии к медикаментам проводится проба с антибактериальными препаратами. Срок исследования от 7 до 10 дней.
- ПЦР или полимеразная цепная реакция позволяет обнаружить ДНК, которая несет в себе все генетические данные бактерии. Обладает высокой точностью и позволяет определить гарднереллы в мазке даже при их незначительном количестве. Недостатком данного способа является невозможно установить количество бактерий, которые являются условно-патогенными и при незначительном количестве не опасны.
- Цитологическое исследование необходимо для своевременной диагностики онкологии шейки матки. Благодаря ему также обнаруживают воспалительные поражения тканей половых органов и вагиноз.
- КАЧ (анализ мазка Хей-Айсон) позволяет подтвердить патогенную флору, которая привела к нарушению флоры влагалища.
Расшифровка результатов
Анализ ПЦР может содержать только два результата: положительный или отрицательный. В первом случае подтверждается бактериальный вагиноз и для выявления количества патогенного микроорганизма и назначения терапии проводятся дополнительные более информативные исследования, например, бактериологический посев микрофлоры влагалища.
Важным анализом на гарденелез является бакпосев, который позволяет определить не только количественный показатель патогенной флоры, но и ее чувствительность к антибактериальным препаратам. В ходе такого анализа норма гарднереллы составляет 10 в 5 степени.
При микроскопическом исследовании мазка на флору в Инвитро, прочих частных и государственных медицинских учреждениях кроме гарднерелллы во внимание берутся такие показатели, как:
- Плоский эпителий в норме присутствует не более 10 единиц в поле зрения. При увеличении его количества можно предполагать развитие воспалительных процессов в половых органах. Отсутствие эпителия в мазке косвенно указывает на гормональный сбой или дистрофию тканей влагалища.
- Лейкоциты в норме во влагалище не превышают 10 единиц в поле зрения, а в цервикальном канале 30, при выявлении белых телец в количестве более 10 есть основания предполагать развитие инфекционно-воспалительных процессов в половых органах.
- Стафилококк и стрептококк в норме отсутствуют или не превышают показателей 10 в 4 степени и 10 в 5 степени КОЕ соответственно. При превышении показателей ставится диагноз гнойное воспаление половых органов. Требуются дополнительные исследования.
- Палочки Додерлейна и лактобактерии в норме составляют 95-98% всей микрофлоры влагалища. Снижение их количества и увеличение атипичных клеток, кокков свидетельствует о дисбиозе влагалища, воспалительных патологиях и прочих патогенных процессов в половых органах.
- Атипичные или ключевые клетки – склеенные между собой клетки эпителия или вагинальные гарднереллы, которые в норме отсутствуют или не превышают показатель 10 в 5 степени. При росте их уровня ставится диагноз вагиноз, при этом отмечается снижение лактобактерий.
- Кандида – дрожжевая грибковая инфекция, которая у здоровой женщины не обнаруживается или не превышает показатель 10 в 4 степени КОЕ. Превышение уровня – признак кандидоза или молочницы.
- Трихомонада в норме отсутствует. Если в анализах определяется незначительное количество патогенных клеток ставится диагноз трихомониаз.
- Гонококки в норме отсутствуют. При их обнаружении ставится диагноз гонорея.
- Кишечная палочка – в норме отсутствует или видна в поле зрения в количестве не более 10 в 4 степени. При росте показателя совместно с высоким уровнем лейкоцитов, кишечная палочка считается возбудителем воспалительного количества.
С помощью показателей, описанных выше, определяется степень чистоты влагалища:
- Нулевой уровень свидетельствует об отсутствии инфекционных агентов в микрофлоре влагалища.
- Первый уровень – среда половых органов находится в пределах нормы. Имеется незначительное количество гарднереллы или других бактерий.
- Второй уровень – количество патогенных микроорганизмов в пределах нормы, однако отмечается снижение уровня лактобактерий.
- Третий уровень – концентрация гарднереллы незначительно превышает допустимый уровень, палочка Додерлейна отсутствует или имеется в незначительном количестве.
- Четвертый уровень – концентрация лактобактерий в микрофлоре влагалища менее 6%, высокий уровень патогенных микроорганизмов.
Gardnerella vaginalis – условно патогенный микроорганизм, который в незначительном количестве не нарушает микрофлору половых органов и не несет опасность. Однако при превышении допустимой нормы (10 в 5 степени КОЕ) на фоне предрасполагающих факторов может стать причиной воспалительных патологий и привести к другим осложнениям. Для диагностики необходимо сдать мазок для определения микрофлоры влагалища. С этой целью назначается бакпосев, ПЦР, микроскопическое и цитологическое исследовании, качественный анализ биологического материала.
Нашли ошибку в тексте? Выделите ее и нажмите Ctrl+Enter, и мы все исправим!
Гарднерелла: симптомы, лечение гарднереллеза
Нормальная микрофлора влагалища является одним из основных факторов неспецифической резистентности. В норме влагалище здоровой женщины представляет собой резервуар, вмещающий как аэробную, так и анаэробную микрофлору. Однако количество первой в десять раз превышает количество второй. Её основными представителями являются лактобациллы, продуцирующие перекись водорода и молочную кислоту, препятствующую размножению условно-патогенных бактерий. Однако некоторые эндогенные и экзогенные факторы могут спровоцировать развитие воспалительного синдрома, обусловленного вагинальным дисбалансом. Состояние, при котором молочно-кислые бактерии полностью замещаются факультативными анаэробами, присутствующими лишь в незначительном количестве во влагалищном секрете здоровой женщины, в клинической практике называется бактериальным вагинозом или гарднереллезом. Это достаточно распространенная патология, которая диагностируется у 30-35% пациентов со смешанными урогнетитальными инфекциями.
Возбудитель гарднереллеза
Влагалищная гарднерелла (Gardnerella vaginalis), провоцирующая развитие гарднереллеза, впервые была выделена у пациенток, страдающих вагинитом в 1955 году Дьюксоном и Гарднером, которые её назвали гемофильной вагинальной палочкой. Данный микроорганизм представляет собой неподвижную, лишенную капсулы полиморфную безъядерную грамвариабельную палочку (или коккобациллу), достигающую в длину 2 мкм и 0,7-0,9 мкм в поперечнике. Эта бактерия может быть представлена в виде кокков или небольших палочек, покрытых тончайшей клеточной стенкой и наружным микрокапсулярным слоем. Следует отметить, что для некоторых гарднерелл характерно мембранное строение клеточной стенки, как у грам-отрицательных бактерий, а у других – гомогенное – как у грам-положительных микроорганизмов.
Это факультативный анаэроб, который способен размножаться даже при полном отсутствии кислорода, в процессе своей жизнедеятельности продуцирующий аминокислоты и уксусную кислоту. В том случае, когда в силу определенных причин гарднерелла становится агрессивной и начинает бесконтрольно размножаться, продукты её жизнедеятельности за короткий срок изменяют рН влагалища и способны полностью уничтожить всю его нормальную микрофлору, из которой 90% в норме приходится на молочно-кислые бактерии.
На открытых поверхностях возбудитель может сохранять свою жизнеспособность в течение 3-6 часов (в слое слизистых выделений), а в неактивных формах (в виде спор) – до года. Поэтому существует опасность заражения гарнереллезом в общественных туалетах и в непроточных водоемах.
Примечание: гарднерелла – это условно-патогенный микроорганизм, который может присутствовать у большинства здоровых женщин, не проявляя патогенных свойств.
Распространенность заболевания
По статистике ВОЗ, гарднереллез является одним из наиболее распространенных заболеваний, передающихся половым путем, от которого чаще всего страдают женщины репродуктивного возраста. У мужчин такое недуг встречается гораздо реже. Данная патология выявляется у 30-80% пациентов, страдающих различными воспалениями половых органов, а также она выявляется в ходе профилактических обследований у четверти здоровых женщин.
Факторы риска, источники заражения и пути передачи гарднереллеза
По мнению специалистов, развитие гарднереллеза находится в прямой зависимости от характера половой жизни. Данная патология никогда не выявляется у здоровых девственниц, а также у женщин, не страдающих вагинитом. Поэтому к предрасполагающим факторам относят:
- беспорядочную половую жизнь;
- перенесенные ранее инфекции;
- нарушения менструального цикла;
- использование внутриматочных контрацептивов;
- длительный прием антибактериальных препаратов и антидепрессантов, приводящих к дисбалансу влагалищной микрофлоры;
- применение противозачаточных средств, нарушающих гормональный фон;
- использование при спринцевании хлорсодержащих антисептиков;
- стрессовые ситуации;
- длительное ношение плотно прилегающего к телу синтетического белья;
- отсутствие в пищевом рационе кисломолочных продуктов, являющихся источником лактобактерий.
Следует подчеркнуть, что чаще всего гарднереллез протекает на фоне других урогенитальных инфекций (трихомониаз, гонорея, хламидиоз, уреаплазмоз и пр.).
Основной путь передачи – половой. Вместе с тем инфекция может передаться от зараженной матери к ребенку при прохождении через инфицированные родовые пути, или вследствие внутриутробного инфицирования.
Патогенез гарднереллеза
Вирулентность данного микроорганизма относительно невелика, и только у некоторых штаммов гарднерелл конечным продуктом ферментации является уксусная кислота и аминокислоты. Другие же продуцируют в ходе своей жизнедеятельности молочную и муравьиную кислоту. Поэтому некоторые авторы склоняются к тому, что данная бактерия не обладает патогенными свойствами, а относится к сапрофитам урогенитального тракта.
В ходе полового контакта со страдающей гарднереллезом женщиной (или бактерионосительницей), возбудитель попадает на мужской уретральный эпителий, а впоследствии, при очередном половом контакте, инфицирует или реинфицирует женские половые пути.
Прикрепляясь к поверхности многослойного плоского эпителия, гарднереллы способны образовывать характерные формирования, которые в клинической практике называются «ключевыми клетками». Именно их обнаружение в ходе бактериоскопического исследования мазков из половых органов имеет важное диагностическое значение.
К сожалению, до сегодняшнего дня патогенез данного заболевания до конца не ясен. Тем не менее, ученые установили, что гарднерелла повреждает эпителиальные клетки влагалища, а также вызывает аутолиз (растворение) фагоцитов.
Клинические формы гарднереллеза
Для описания клинических признаков урогенитальных патологий, спровоцированных анаэробными микроорганизмами, ученые разработали специальную классификацию, включающую следующие формы гарднереллеза:
- Бактериальный вагиноз;
- Бактериальное поражение верхних половых путей;
- Гарднереллез женских мочевыводящих путей;
- Гарднереллез мужских мочевыводящих путей;
- Гарднереллез беременных.
Бактериальный вагиноз
Это, по оценкам специалистов, самая распространенная клиническая форма заболевания. Как правило, в ходе диагностического исследования в отделяемом из половых органов наряду с гарднереллой обнаруживаются и другие представители анаэробной микрофлоры (лептострептококки, мобилункус, бактероиды и пр.), но, вместе с тем, в нем отсутствуют возбудители, передающиеся половым путем. У 50% пациентов при бактериальном вагинозе основными симптомами являются выделения с неприятным запахом тухлой рыбы. У другой половины больных при данной форме патологии объективные и субъективные симптомы не выявляются.
Неприятный запах, по мнению специалистов, возникает по причине образования биогенных аминов в процессе метаболизма гарднерелл и других неспорогенных анаэробов. Путресцин и кадаверин (патологические амины), представленные в виде нелетучих солей, в процессе подщелачивания становятся быстро испаряющимися веществами, источающими сильный рыбный запах.
Гарднереллез верхних половых путей
При данной форме патологии инфицирование может происходить непосредственно через околоматочную клетчатку, а также лимфогенно или гематогенно. Известны случаи, когда данная форма гарднереллеза становилась причиной развития эндометритов и сальпингоофоритов, а также некоторые авторы описывают случаи заражения крови гарднереллами (гарднереллезной септицемии), приводящей к тяжелейшему эндотоксическому шоку и послеоперационным осложнениям у гинекологических больных.
Примечание: именно поэтому всех женщин, готовящихся на операцию, следует в обязательном порядке обследовать на бактериальный вагиноз.
Гарднереллез мочевыводящих путей у женщин
Развитие данной патологии объясняется анатомической близостью влагалища и уретры, вследствие чего происходит перенос возбудителя из половых органов в мочевые пути.
Имеются данные о том, что гарднереллу очень часто выделяют из мочи практически здоровых женщин. Однако диагностировать гарнереллез можно только в том случае, когда в одном миллилитре мочи, взятой катетером, насчитывается более 1000 КОЕ бактерий.
Гарднереллез мужских мочевыводящих путей
У мужчин данное заболевание встречается не так часто, как у женщин. Зачастую при обнаружении гарднереллы в купе с другими бактероидами, у представителей сильного пола воспаляется передняя уретра. В данном случае отмечается вялое течение уретрита, со слабо выраженной клинической симптоматикой. Пациенты жалуются на возникновение скудных слизисто-серозных выделений, без болей и дискомфорта. Осложнения гарднереллеза у мужчин в клинической практике встречается очень редко. Имеются единичные сообщения о развитии гарднереллезного простатита, цистита, эпидидимита и пиелонефрита. При манифестных формах заболевания особенности клинического течения, как правило, определяют именно те патогенные микроорганизмы, с которыми возбудитель гарднереллеза вступает в ассоциацию.
Примечание: мужчины, которые страдают бессимптомной (или малосимптомной) формой заболевания, зачастую являются источниками заражения своих половых партнерш.
Гарднереллез беременных
В гинекологической практике данная форма патологии встречается почти у 20% беременных. Но к счастью внутриматочная инфекция развивается очень редко, так как в этот период возрастают активные защитные механизмы. Вместе с тем некоторые авторы отмечают возможность умеренного подавления клеточного иммунитета. Очень часто бактериальный вагиноз становится причиной различных нарушений при протекании беременности, а также заболевание может спровоцировать развитие послеродовых осложнений.
У женщин с диагнозом «гарднереллез» в два раза чаще случаются преждевременные роды, причем у десятой части рожениц в амниотической жидкости обнаруживают гарднереллу и другие микроорганизмы, хот я в норме она должна быть стерильной.
Также существуют доказательства того, что бактериальный вагиноз может быть связан с хорионамнионитом (гнойно-септическим осложнением, также приводящим к преждевременным родам), а еще, по мнению некоторых специалистов, гарднерелла может спровоцировать послеродовой или послеабортный сепсис.
Симптомы гарднереллеза у женщин
При развитии патологического процесса у пациенток возникают обильные, неприятно пахнущие пенящиеся вагинальные выделения, а также, в ходе проведения специальных лабораторных тестов выявляется снижение кислотности влагалищной среды. Зачастую женщины жалуются на сильный зуд и жжение в области наружных гениталий и промежности.
Вместе с тем у пациенток отмечается гиперемия слизистой оболочки влагалища, уретры и шейки матки. При свежем остром гарднереллезе вагинальные выделения очень обильные, густые и гомогенные, бело-серого цвета, а выделения из уретры и цервикального канала достаточно скудные.
В том случае, когда в патологический процесс вовлекается полость матки и фаллопиевы трубы, диагностируется сальпингит.
Симптомы гарднереллеза у мужчин
У представителей сильного пола данное заболевание зачастую протекает исключительно в виде воспаления наружных половых органов. Как правило, возбудитель гарднереллеза уже через двое или трое суток выводится из мочевыводящих путей (при их здоровом состоянии). Однако при переохлаждении, сниженном иммунитете или при наличии сопутствующих патологий, гарднерелла становится агрессивной, начинает размножаться и приводит к воспалению слизистой оболочки уретры.
Иногда заболевание протекает в скрытой форме, ничем себя не проявляя, и, при отсутствии жалоб, мужчина становится бактерионосителем.
Симптоматика гарднереллеза у мужчин полностью схожа с симптоматикой уретрита. При воспалении слизистой оболочки мочеиспускательного канала в уретре возникает чувство жжения, дискомфорт в процессе мочеиспускания, а также появляются слизисто-серозные выделения.
Диагностика гарднереллеза
Как правило, при постановке диагноза учитываются жалобы пациентов, данные осмотра и результаты лабораторных исследований.
В качестве материала для исследования используется отделяемое из уретры, цервикального канала, стенок и сводов влагалища, а также моча.
В ходе бактериоскопии в мазках больных при отсутствии лейкоцитов выявляются ключевые клетки (клетки плоского эпителия, практически «облепленные» грамвариабельными коккобактериями). Также отмечается снижение кислотности влагалищной среды (рН>4,5), результат аминного теста положительный, молочно-кислые бактерии полностью отсутствуют, а число анаэробов превышает количество аэробов.
Примечание: зачастую гарднереллез развивается у тех пациенток, которым ранее назначалось антибактериальное лечение кольпита. В таком случае именно антибиотики усугубляют течение патологического процесса.
На современном этапе наряду с бактериоскопическими исследованиями для выявления гарднереллеза используются микробиологические методики, ДНК-гибридизация, РИФ (реакция иммунофлюоресценции) и ПЦР.
Лечение гарднереллеза
Лечение гарднереллеза проводится в комплексе, направленном на восстановление нормальной микрофлоры влагалища и создание оптимальной физиологической среды. Местное лечение, как правило, должно проводиться не менее десяти дней. Оно предусматривает обработку влагалища раствором мирамистина или метронидазолом, а также пациенткам назначаются спринцевания содовым раствором и ромашковые ванночки.
В обязательном порядке в процессе лечения показано применение препаратов, стимулирующих иммунные силы организма и витаминных комплексов.
При системной терапии назначаются специализированные препараты, в которых активным действующим веществом является метронидазол или клиндамицин. Также специалисты рекомендуют использовать биогенные стимуляторы и медикаментозные средства, нормализующие микробиоценоз кишечника и влагалища.
При острой форме патологического процесса пациентам назначается двухнедельная антибактериальная терапия. Однако иногда для полного излечения требуется как минимум два, а иногда и три курса лечения.
Главной проблемой, возникающей при лечении гарднереллеза, является то, что возбудитель данного заболевания является условно-патогенным микроорганизмом, а поэтому, обитая в организме абсолютно здоровой женщины, под воздействием неблагоприятных факторов он становится агрессивным и начинает бесконтрольно размножаться.
Гарднерелла – это микроорганизм, резистентный к действию тетрациклинов и макролидов. Поэтому прежде, чем приступать к лечению, следует пройти все необходимые обследования и сдать бакпосев на чувствительность к антибактериальным препаратам.
Неплохо себя зарекомендовало народное лечение гарднереллеза. Для того чтобы избавиться от этого недуга, народные целители рекомендуют применять травяные сборы. Однако необходимо понимать, что для достижения стойкого эффекта их нужно принимать очень долго (6-12 месяцев). В качестве биогенных стимуляторов, способствующих нормализации влагалищной и кишечной микрофлоры в народной медицине используют лимонник, аралию и левзею сафроловидную.
Специалисты настоятельно рекомендуют не пренебрегать лечением гарднереллеза, так как патологический процесс может перейти в хроническую стадию и спровоцировать развитие различных осложнений.
Профилактика гарднереллеза
Женщинам, страдающим бактериальным вагинозом, следует обратить внимание на состояние иммунной системы, так как именно снижение иммунитета влечет за собой нарушение микрофлоры влагалища и приводит к гормональным нарушениям. К основным способам профилактики гарднереллеза относят здоровый образ жизни, правильное питание, нормальный сон, регулярные прогулки на свежем воздухе. Очень важно соблюдать гигиену наружных половых органов и не допускать переохлаждений. При случайных половых контактах не следует забывать о средствах индивидуальной защиты, а также не лишним будет в течение двух часов обработать наружные половые органы специальными антисептиками.
Практически все специалисты рекомендуют в целях профилактики гарднереллеза отказаться от ежедневных спринцеваний, так как такие процедуры не только могут спровоцировать развитие аллергических реакций, но и раздражают слизистую оболочку влагалища, смывая естественную смазку и изменяя кислотность, что, в конечном итоге приводит к угнетению естественной микрофлоры.
Для того чтобы во влагалище в достаточном количестве находились молочно-кислые бактерии, в пищевом рационе должны присутствовать разнообразные овощи и фрукты, квашеная капуста, биокефиры и йогурты.
В обязательном порядке следует обратить внимание на состояние микрофлоры кишечника. В случае нарушения необходимо провести специальный курс лечения, так как условно-патогенные микроорганизмы, обитающие в кишечнике, без труда преодолевают тонкую стенку и проникают во влагалище. По мнению специалистов, лечение гарднереллеза у пациенток с кишечным дисбактериозом является самым сложным.
При проведении адекватного своевременного лечения уже через две или четыре недели микрофлора влагалища полностью восстанавливается. В противном случае патологический процесс может спровоцировать воспаление придатков, развитие различных осложнений при беременности, преждевременные роды и женское бесплодие.